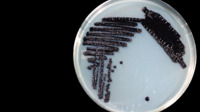

Hauptseite
An der Küste
Alternativen für Leder
Im Labor
Innovative Materialien
Im Gewächshaus
Umweltfreundliche Färbemittel
In der Werkstatt
Biobasierte Schutzfilme
1.1 Küste – Neues/Veganes Leder, Leder züchten
Leder aus dem Labor
Zudem kommen bei den notwendigen Gerbverfahren meist ätzende Chemikalien zum Einsatz. Mangelt es in den Manufakturen an Schutzstandards, kann der Gebrauch Schäden an Umwelt und an der Gesundheit von Mitarbeitern verursachen.
Während bei den Lederproduzenten in Deutschland laut Branchenverband sehr hohe Standards vorliegen, haben Journalisten immer wieder Missstände in Betrieben aufgedeckt, vor allem außerhalb Europas.
Die stärksten Zuwächse verzeichnet der Industriezweig in Asien und Lateinamerika.
Leder aus dem Labor
Hier geht es um eine tierische Innovation, die in ihrem Endzustand die gleichen Eigenschaften wie herkömmliches Leder aufweist. Der große Unterschied liegt im Ursprung und in der Herstellung des Materials.
Für die neue Variante muss kein Rind geschlachtet werden. Durch ein nicht verletzendes Verfahren (Biopsie) werden ihm wenige Zellen entnommen. Es folgt ein biotechnologisches, hoch spezialisiertes Verfahren, das vereinfacht in drei Schritten dargestellt werden kann...
Leder aus dem Labor
2.) Anschließend werden die Zellen in einem Bioreaktor mit den richtigen Nährstoffen „gefüttert“, um das Wachstum anzuregen. Dieser Prozess dauert nur wenige Wochen.
3.) Nach dem Aufenthalt im Bioreaktor sind die einzelnen Zellen zu einer Haut gereift, die bereit für ein Gerbverfahren ist.
Laut Wissenschaftlern handelt es sich um ein relativ ressourcenschonendes Verfahren, das jedoch noch keine Marktreife erlangt hat. Internationale Forscherteams arbeiten intensiv daran, dass sich das ändert.
Aus Tierzellen lassen sich auch noch ganz andere Produkte herstellen.
Leder aus dem LaborFleisch aus Zellkultur
Die Lösung könnte Fleisch aus Zellkultur sein. Forschende arbeiten weltweit daran, tierische Zellen im Labor zu züchten, um Produkte wie Chicken-Nuggets, Fischstäbchen oder gar Steak auf den Teller zu bringen.
Wie die Herstellung von Fleisch und Fisch im Labor funktioniert, erfährst du in den folgenden Videos.
Leder aus dem LaborDer Laborfischer
Die Zellen werden aus dem Muskelfleisch entnommen und in Bioreaktoren vermehrt. In den nächsten Jahren sollen die ersten Produkte auf dem Markt sein. Zunächst als Hybrid-Produkte, mit Fischzellen und pflanzlichen Anteilen. Aber auch ein zellbasiertes Fisch-Filet soll in Zukunft auf dem Teller landen.
Dieses Video aus der Porträtreihe DIE BIOPIONIERE zeigt einen Visionär, der mit seiner Forschung dazu beiträgt, die überfischten Meere wieder ins Gleichgewicht zu bringen.
Mehr InformationenZu Bioreaktoren in der Bioökonomie

Mikroalgen-Zucht im Bioreaktor überzeugt
Die Kultivierung von Mikroalgen zur Produktion von Omega-3-Fettsäuren in Photobioreaktoren ist gegenüber der Fischzucht in Aquakultur umweltfreundlicher, wie eine Studie zeigt.
Mikroorganismen im Team kultivieren
Ein neuartiger Bioreaktor soll helfen, den mikrobiellen Artenreichtum zu erforschen und nutzbar zu machen. Ein bundesweiter Forschungsverbund zielt darauf ab, die mikrobiellen Gemeinschaften von Lebensräumen im Labor zu erhalten.
„Wir können mit der Anlage alle Reststoffe verarbeiten“
Daniel Pleißner hat gemeinsam mit Partnern eine mobile und modulare Bioraffinerie entwickelt, die Lebensmittelabfälle noch vor Ort in hochwerte Rohstoffe für neue Lebensmittel umwandeln kann.
Auf dem Weg zur neuen Biotechnologie?
Forschende wollen die Substrate Zucker und Alkohol durch den günstigeren und nachhaltigen Wasserstoff ersetzen.
Hohe Leistung ohne Sauerstoff
Eine mikrobielle Biofabrik mit Zukunft: Forschende wollen das Proteobakterium Shewanella oneidensis für die Herstellung einer wichtigen Plattformchemikalie nutzen.
1.2 Küste – Neues/Veganes Leder, BNC
Sandalen aus Bakterien
Wie das genau funktioniert, erfährst Du auf den folgenden Seiten!
Sandalen aus Bakterien
Bei BNC handelt es sich um ein erneuerbares Material, ein Biopolymer, das aus unterschiedlich langen Fasern besteht. Durch ihre Stärke und die dichte Anordnung entsteht ein flexibles und zugleich robustes Material.
Aufgrund seiner hohen Biokompatibilität findet BNC im medizinischen Bereich vor allem als Material für Wundauflagen und Implantate Anwendung.
In der nachhaltigen Modeszene kommt die Cellulose immer häufiger als Basis für Taschen und Schuhe zum Einsatz.
Wie und woraus die biologisch abbaubare BNC hergestellt wird? Scrolle weiter!
Sandalen aus BakterienScoby – eine wirksame Symbiose
Die Kulturen wachsen in Schichten aus BNC übereinander und arbeiten zusammen: Die Hefen wandeln Zucker in Alkohol, die Bakterien Alkohol in Essigsäure um.
Solche Scobys kommen zum Beispiel auch bei der Herstellung von Essig und Kombucha-Tee zum Einsatz.
Sandalen aus BakterienStart-up ScobyTec auf der HANNOVER MESSE '23
Mehr InformationenZu Materialien aus bakterieller Nanocellulose

ScobyTec
Tierisches Leder kann durch bakterielle Nanocellulose ersetzt werden. Dies hat das interdisziplinäre Forschungsteam der ScobyTec GmbH erkannt und leistet auf dem Gebiet Pionierarbeit. Alles über die junge, erfolgreiche Bioökonomie-Firma aus Sachsen erfährst Du auf dieser Webseite.
Großproduktion von bakteriellem Mikroplastikersatz
Das auf die Entwicklung von bakterieller Cellulose spezialisierte Start-up BIOWEG wird künftig mit dem amerikanischen Unternehmen Ginkgo Bioworks zusammenarbeiten, das von Microsoft-Gründer Bill Gates unterstützt wird.
Mikrobielle Zellfabriken
Dieses Dossier rückt die winzigen Leistungsträger der industriellen Biotechnologie ins Rampenlicht. Für die Kurzporträts bedeutender Bakterien, Hefen und Schimmelpilze hat bioökonomie.de zahlreiche Fachleute als Steckbriefpaten gewonnen.
Bakterien nutzen Wasserstoff für Biosynthese
Jenaer Leibniz-Forschende haben nachgewiesen, dass Bakterien Wasserstoff für mikrobielle Elektrosynthesen nutzen.
Mikroorganismen im Team kultivieren
Ein neuartiger Bioreaktor soll helfen, den mikrobiellen Artenreichtum zu erforschen und nutzbar zu machen. Ein bundesweiter Forschungsverbund zielt darauf ab, die mikrobiellen Gemeinschaften von Lebensräumen im Labor zu erhalten.
1.3 Küste – Neues/Veganes Leder, Ledrige Algen
Ledrige Algen
Algen sind auch eine wertvolle Nahrungquelle, auf die Tiere und auch immer mehr Menschen in Form von Nahrungsergänzungsmitteln oder veganen Fleischalternativen zurückgreifen. Dabei gelten sie aufgrund ihrer hohen Gehalte an Proteinen, Omega-3-Fettsäuren, verschiedenen Mineralstoffen und Vitaminen als besonders gesund.
Neben dem Lebensmittelsektor werden sie inzwischen in vielen weiteren Industriezweigen eingesetzt. Für die Herstellung von Bioplastik stellen sie eine vielversprechende Alternative zu herkömmlichen Kunststoffen dar.
Zudem sind sie eine reichhaltige Quelle für eine breite Palette von Verbindungen, die in der Biotechnologie verwendet werden. Hierzu zählen vor allem Enzyme, Antibiotika und Biokatalysatoren. Durch gezielte Züchtung und genetische Modifikation können Algen so geändert werden, dass sie diese Verbindungen in größeren Mengen produzieren.
Ledrige Algen
Zudem treten Algen immer häufiger als Quelle für natürliche Farbstoffe und biologisch abbaubare Textilfasern in Erscheinung. So findet man beispielweise bereits Kleidung aus der Algenfaser "SeaCell", die besonders weich ist und hautpflegende Eigenschaften besitzen soll.
Im Bereich der Funktionstextilien stärken Algenfasern den UV-Schutz und mindern die Entstehung unangenehmer Gerüche.
Und auch in puncto Lederalternative haben die Organismen einiges zu bieten!
Ledrige Algen
In diesem Video zeigt sie, wie Algen zu lederähnlichen Materialien für die nachhaltige Modeszene werden.
Mehr InformationenZu Algen in der Bioökonomie

Algen als grüne Wasserstoff-Produzenten
Ein deutsch-japanisches Forschungsteam will Algen dazu befähigen, grünen
Wasserstoff ohne Photosynthese auch nachts zu produzieren.
LaborAlgen
Mit Algen kann man Energie erzeugen, Schaumstoff herstellen und Kosmetik
anreichern. Für welche Zwecke René Inckemann Algen einsetzt, erfährst du in diesem Video.
Algen-Tampon
Herkömmliche Einwegtampons bestehen bis zu 90% aus Kunststoff – sie sind damit nicht nur schädlich für die Umwelt, sondern auch für die Gesundheit der Tragenden. Ein neuer Tampon bietet eine nachhaltige Alternative.
Chemie-Rohstoffe aus der Algenfarm
Das Start-up MacroCarbon will auf Gran Canaria die Makroalge Sargassum in Algenfarmen züchten und Grundstoffe für die chemische Industrie liefern. Die Agentur für Sprunginnovationen SPRIND unterstützt das Projekt.
Algenanbau im Meer
Die Ostsee künftig als Ackerfläche nutzen – an dieser Vision arbeiten Forschende der Universität Rostock und nehmen dafür Algen ins Visier.
1. Neue Arten von Leder (Wiese und Küste)
Leder aus dem Labor
Sandalen aus Bakterien
Ledrige Algen
Wundergewebe Chitin
Kokos für Taschen
Leder aus Blättern
Zurück zur Übersicht
1.4 Küste – Neues/Veganes Leder, Pilze. Brotreste, Fasern Chitosan
Wundergewebe Chitin
Chitin bildet die Grundstruktur und besteht aus N-Acetylglucosamin-Einheiten. Chitosan entsteht durch die Entfernung von Acetylgruppen von Chitin.
Beide Stoffe teilen sich besondere Eigenschaften, die sie für verschiedene Industrie- und Wirtschaftsbereiche interessant machen: Sie sind biologisch abbaubar, antimikrobiell und können Flüssigkeiten absorbieren. Diese Charakteristika machen sie zu gefragten Materialien für Anwendungen u. a. in Medizin, Pharmazie, Biotechnologie, Kosmetik und Agrarwirtschaft.
Letztere setzt beispielsweise Pflanzenschutzmittel und Wachstumsförderer mit Chitosan ein. In der Medizin nutzt man den Stoff für sterile Wundauflagen, denn als Trägermaterial beschleunigt er die Regeneration von Knochengewebe, und Cremes reichert Chitosan mit feuchtigkeitsbindenden Eigenschaften aus.
Wundergewebe Chitin
Dabei werden die Vorzüge ihrer Eigenschaften einmal mehr deutlich: Durch ihre Einbindung gewinnen Fasern an Festigkeit und Haltbarkeit. Die antimikrobielle Wirkung hemmt das Wachstum von Mikroorganismen wie Bakterien und Pilzen, was beispielsweise zu einer Reduzierung unangenehmer Gerüche beitragen kann.
Chitosan kann als Schutzfilm auf textilen Oberflächen zudem die Beständigkeit von Farben verbessern und dafür auch direkt in Färbevorgänge eingebunden werden. Farben zu lösen, etwa in Abwassersystemen von Textilfabriken, gelingt mit dem Stoff ebenfalls.
Ein neues Anwendungsbeispiel zeigen Forschende aus Schweden von der Hochschule Borås. Ihnen ist es gelungen, die Brieftasche im Hintergrund mit Hilfe der beiden Stoffe herzustellen. Und zwar nicht aus Chitin und Chitosan, das sie aus Schalentieren gewinnen, sondern …
Wundergewebe Chitin
Die Besonderheit des Rhizopus-delemar-Myzels liegt darin, dass in seinen Zellwänden große Mengen Chitosan und Chitin eingelagert sind, welche die Fäden auffallend reißfest machen.
Das Team macht sich diese Eigenschaften zunutze. Für die Zucht des Schimmelpilzes sammelt es altes, unverkäufliches Brot. Dieses wird zerkleinert, mit den Pilzsporen in einer Nährlösung vermischt und für zwei Tage in einem Bioreaktor fermentiert.
Das Resultat ist eine fadenreiche Masse, die sich v. a. nach dem Entfernen von Fetten und Proteinen zu einem Gel wandelt. Wird es getrocknet und gewalzt, gewinnt man ein lederähnliches Material, es können aber auch die nassen Fäden extrahiert und zu Garn gesponnen werden.
Mehr InformationenZu Chitosan und Chitin in der Bioökonomie

Mit Chitosan Gewässer reinigen
Dresdner Leibniz-Forschern ist es erstmals gelungen, verockerte Gewässer wieder aufklaren zu lassen: Sie nutzten dazu das Biopolymer Chitosan als Flockungsmittel.
Den Chitin-Code knacken
Wie wird Chitin von der Natur erzeugt? Diese Fragen wollen Forschende beantworten, um das Biopolymer für die Medizin nutzbar zu machen.
Biobasierte Verpackungsfolien für Lebensmittel
Partner aus Forschung und Wirtschaft wollen mehrlagige Verpackungsmaterialien auf Basis von Chitosan entwickeln und zugleich eine entsprechende Methode zur Qualitätskontrolle erarbeiten.
Krabbenschalen für den Pflanzenschutz
Mit Chitosan aus Krabbenschalen wollen Münsteraner Forscher gemeinsam mit indischen Kollegen neue Pflanzenschutzmittel herstellen, die sowohl für Industrieländer als auch für Kleinbauern in der Dritten Welt nützlich sind.
Bio-Verbundstoff aus Flachs und Chitosan
Forschende haben einen neuen Bio-Verbundwerkstoff entwickelt, der aus CO2-neutralen Rohstoffen besteht und biologisch abbaubar ist.
1.6 Küste – Neues/Veganes Leder, Leder Reststoffe
Kokos für Taschen
Ihre luftige Struktur, ihre Fähigkeit, Wasser gut zu halten und ihr hoher Gehalt an Lignin machen die Fasern etwa zu einem beliebten Substrat für Pflanzen. So kann Blumenerde, die häufig noch immer auf Torf basiert, umweltfreundlich ersetzt werden.
Wie Fasern von Kokosnüssen und anderen pflanzlichen Quellen für biobasierte Textilien nutzbar gemacht werden können, erfahrt ihr in dieser Geschichte.
Kokos für Taschen
Im Gegensatz zu vielen anderen pflanzlichen Materialien mit hoher Festigkeit, enthält Mirum keine Kunststoffe, sondern vor allem landwirtschaftliche Reststoffe wie Kokosfasern sowie Naturkautschuk und natürliche Farbpigmente, die beispielsweise aus Kohle gewonnen werden.
Das Material ist eines der wenigen seiner Art, das man komplett recyceln und ohne Qualitätsverlust mehrfach für neue Mirum-Artikel nutzen kann.
Da es biobasiert ist, verbleibt nach dem Ausstieg aus dem geschlossenen Produktionszyklus kein Müll, der einer thermischen Verwertung mit hohem CO2-Austoß zugeführt werden muss.
Kokos für TaschenPflanzliche Lederalternativen
Mehr InformationenZu landwirtschaftlichen Reststoffen

„Landwirtschaft sollte Dreh- und Angelpunkt einer echten Kreislaufwirtschaft werden“
Das Unternehmen von Torben Schierbecker akquiriert und vermittelt biogene Roh- und Reststoffe zur Weiterverarbeitung, um die Kreislaufwirtschaft in Schwung zu bringen.
Reisstroh als Rohstoffquelle nutzen
Bislang werden Ernteabfälle meist verbrannt und setzen CO2 und Feinstaub frei. Geeignete Bioraffinerien könnten das ändern.
Isolierverpackung
Stroh stellt eine nachhaltige Alternative zu den handelsüblichen Isolierverpackungen aus Styropor dar und ermöglicht es somit, den Verpackungsmüll deutlich zu reduzieren.
Verpackungen aus Pflanzenblättern
Auf der Suche nach Alternativen zu Plastik wollen Forscher Verpackungen aus Blättern von Bananen und Wasserhyazinthen weiterentwickeln, um Lebensmittel besser zu schützen.
Innovationspreis für Fasern aus Agrarreststoffen
Für die Entwicklung eines Verfahrens zur Naturfaserherstellung sind das CleanTech-Start-up BIO-LUTIONS und die Zelfo Technology in Schwedt mit dem Brandenburger Innovationspreis ausgezeichnet worden.
1.7 Küste – Neues/Veganes Leder, Leder Blätter
Leder aus Blättern
Durch Filterung von Schadstoffen aus der Luft verbessern sie die Luftqualität und fördern somit Gesundheit und Wohlbefinden von Menschen und Tieren. Und in Städten haben Bäume dank der Verdunstung von Wasser über ihre Blätter einen kühlenden Effekt.
Im medizinischen Bereich kommen z. B. Bestandteile von Weidenblättern für die Herstellung von Aspirin zum Einsatz, die ätherischen Öle von Eukalyptusblättern können Atemwegserkrankungen lindern.
Die nachhaltige Modeszene hat ebenfalls einen Blick auf Blätter geworfen. Auf welche genau, und was sie damit anstellt, erfährst du im folgenden Video.
Leder aus Blättern
Mehr InformationenZu Blättern in der Bioökonomie

Verpackungen aus Pflanzenblättern
Auf der Suche nach Alternativen zu Plastik wollen Forscher Verpackungen aus Blättern von Bananen und Wasserhyazinthen weiterentwickeln, um Lebensmittel besser zu schützen.
So funktioniert der pflanzliche Sonnenschutz
Auch Pflanzen schützen ihre Zellen durch Farbpigmente vor zu viel Sonne. Das Signal dazu geben Zucker aus der Photosynthese.
Das Mikrobiom von Eichenblättern verstehen
Im Rahmen des hessischen Forschungsförderprogramms LOEWE werden Marburger Forschende die mikrobiellen Gemeinschaften auf Laubblättern vermessen.
Mit Nutzhanf zur klimafreundlichen Landwirtschaft
Forschende untersuchen, ob der Anbau von Nutzhanf als Zwischenfrucht zur Verringerung der Nitratkonzentration im Boden führen kann und ob Hanfblätter den Sojaanteil im Futter von Milchkühen ersetzen können.
Tabakpflanzen zu Biofabriken
In einem EU-Projekt wollen Forscher Tabakblätter in pflanzliche Biofabriken verwandeln. Sie sollen gesunde Inhaltsstoffe für Arznei- und Kosmetikprodukte liefern.
2.1 Biobasierte Stoffe/Materialien (Labor) 3D-Druck
3D-Druck in der BioökonomieGedruckte Laborbrillen
Wie 3D-Druck funktioniert, was seine Vorteile sind und wie er auch in der Bioökonomie eingesetzt wird, erfährst Du auf den folgenden Seiten.
3D-Druck in der Bioökonomie
Dies eröffnet vielfältige Anwendungsbereiche, von ökologisch verträglichen Verpackungslösungen über medizinische Implantate bis hin zur Schaffung komplexer architektonischer Strukturen.
Ein großer Vorteil von 3D-Druck ist die individuelle, kostengünstige Produktion geringer Stückzahlen. Auch in vielen Laboren, in denen bioökonomische Forschung betrieben wird, kommt er deshalb inzwischen zum Einsatz.
3D-Druck im LaborEinsatz in der Pflanzenforschung
Als Ausgangsmaterial dient ein sogenanntes Filament, eine lange aufgerollte Faser. Biobasierte Filamente sind nicht aus herkömmlichem Kunststoff aus fossilen Rohstoffen, sondern zum Beispiel aus Polymilchsäure. Diese hat für den 3D-Druck besonders gute Eigenschaften.
Starte das Video, um im Zeitraffer zu sehen, wie eine maßgeschneiderte Versuchskammer für Pflanzen gedruckt wird.
3D-Druck im LaborPflanzenforschung im Weltraum
Für das Projekt MISAT sollen die Versuchskammern sogar auf der Internationalen Raumstation ISS zum Einsatz kommen, um den Einfluss von geringer Schwerkraft auf bestimmte Phänomene in den Wurzeln zu untersuchen.
Tortenkunst aus dem 3D-Drucker
Mehr InformationenZum 3D-Druck in der Bioökonomie

Per 3D-Druck zum biobasierten Produkt
3D-Druck ist zu einer Schlüsseltechnologie einer immer stärker digitalisierten Industrieproduktion geworden. Dieses Dossier erläutert das Potenzial des 3D-Drucks zur Fertigung biobasierter Produkte in der Lebensmittelherstellung, der Werkstofftechnik und der Medizin.
Bioabbaubare Verpackungen aus Popcorn
In Göttingen wurde ein Verfahren entwickelt, mit dem sich nachhaltige Verpackungen aus Popcorngranulat im 3D-Druck herstellen lassen.
Mückenschutz: Ein Ring, sie zu vertreiben
Forschende aus Halle haben mithilfe eines 3D-Druckers ein Insektenschutzmittel in einem Biopolymer verkapselt und daraus einen Fingerring geformt, der vor Stechmücken schützt.
Mikroplastik-Filter nach Fischkiemen-Art
Nach dem Vorbild von Fischkiemen wollen Forschende einen nachhaltigen Filter entwickeln, der Mikroplastik aus Waschmaschinen siebt.
Cellulose-Endlosfasern aus dem 3D-Drucker
Eine neue Methode ermöglicht es, Bioverbundwerkstoffe aus Fasern zu erzeugen, die hitzeempfindlich sind.
2.2 Biobasierte Stoffe/Materialien (Labor) Wurzeln
Wurzelkleid
Spezielle Wurzeln ermöglichen Luftatmung in feuchten Böden und reagieren auf wechselnde Umweltbedingungen – sofern die Schwankungen nicht zu groß sind. In trockenen Gebieten reduzieren sie das Risiko von Wüstenbildung und sie fördern die Biodiversität, indem sie Lebensraum für Bodenlebewesen bieten.
In Industrie und Wirtschaft finden sich vor allem in den Bereichen Ernährung, Kosmetik und Gesundheit verschiedenste Anwendungsbeispiele: Wichtige Nahrungspflanzen wie Kartoffeln ernähren mit ihren Wurzelknollen viele Menschen. Wurzelbestandteile von Baldrian kommen in medizinischen Präparaten vor, Parfums enthalten häufig ölbasierte Wurzelextrakt.
Wurzelkleid
Diese Strukturen machen sich Künstlerinnen und Künstler zunutze und mischen den Wurzeln beispielsweise Gips bei, um Skulpturen zu fertigen. Zu dekorativen Zwecken werden sie in Collagen eingebunden und schaffen interessante Kontraste und Texturen in Kombination mit anderen Materialien wie Leinwand, Papier oder Metall.
Auch im Textildesign hat man auf sie ein Auge geworfen. Filigrane Natur-Kreationen mit Wurzeln sind nicht für Sturm und Starkregen geeignet, als dekorativer Blickfang jedoch allemal. Sieh selbst!
WurzelkleidMit Wurzeln kreativ werden
In ihrem Video zeigt die Wissenschaftlerin vom King's College London, dass man mit Wurzeln beeindruckende filigrane Kunst- und Kleidungsstücke fertigen kann.
Mehr InformationenZu Wurzeln in der Bioökonomie

So reguliert das Protein TOR das Wurzelwachstum
Das Signalmolekül TOR erkennt, ob genügend Zucker vorhanden ist, um neue Wurzeln zu entwickeln.
Rhizosphäre für die Zukunft fit machen
Moderne Agrarsysteme müssen den Herausforderungen des Klimawandels gewachsen sein. Im wurzelnahen Bereich älterer Nutzpflanzensorten suchen Forschende nach dem Schlüssel für die Bewältigung von Umweltstress und mehr Ertragssicherheit.
Kosmetik aus Pflanzenwurzeln
Clariant kooperiert mit einem französischen Unternehmen, um Pflanzeninhaltsstoffe aus Wurzeln zu gewinnen.
Wurzeln für Bodenleben in den Tropen wichtiger als gedacht
Ohne Kontakt zu Wurzeln leben im Boden ein Drittel weniger Zersetzer. Das haben Biodiversitätsforschende aus Deutschland bei Studien in tropischen Regenwäldern und Plantagen herausgefunden.
Rolle der Feinwurzeln für Pflanzenwachstum
Das Aussehen der Pflanze verrät einer Studie zufolge nichts über ihre Wurzeln. Den Merkmalen der Feinwurzeln sollte aber künftig bei Entwicklungsprognosen mehr Beachtung geschenkt werden.
2. Biobasierte Stoffe/Materialien (Labor)
Gedruckte Laborbrillen
Wurzelkleid
Fasern aus Stroh
Lauch und Banane
Fasern aus Fermentation
Pelz aus Stammzellen
Zurück zur Übersicht
2.3 Biobasierte Stoffe/Materialien (Labor) Stroh
Fasern aus Stroh
In besonders großen Mengen ist es in Bäumen, Gräsern, Bambus, Baumwolle, Flachs, Hanf und Jute vorhanden und damit in Pflanzen, die vor allem für die Herstellung von natürlichen Textilfasern wie Baumwolle, Viskose und Lyocell herangezogen werden.
Wie nachhaltig die jeweilige Verwendung des Rohstoffs ist, hängt unter anderem von seiner Aufzucht inklusive Wasser- und möglichem Pestizideinsatz ab und vor allem auch von den Verfahren, samt Chemikalieneinsatz, die für die Umwandlung zu einer weichen Faser vonnöten sind.
Im Fall des folgenden Rohstoff-Kandidaten weiß man, dass nicht nur seine Verarbeitung zu einer Faser besonders umweltfreundlich und ressourcenschonend ist, sondern auch seine Nutzung, da es sich um einen Reststoff handelt.
Fasern aus Stroh
In der Textilindustrie landet bisher nur ein kleiner Teil. Traditionell setzt man es als Basis oder zusätzliches Material für Hüte, Taschen oder Schuhe ein. In seiner ursprünglichen Erscheinungsform sind seine Einsatzmöglichkeiten darüber hinaus begrenzt.
Verändert man die Struktur des Strohs jedoch mit neuen technologischen Verfahren, entstehen weitere Anwendungsgebiete. Ein beeindruckendes Ergebnis ist der Schal auf der rechten Seite (aktiviere unten die Vorher/Nachher-Funktion).
Scrolle weiter für mehr Informationen!
Fasern aus Stroh
bei den Deutschen Instituten für Textil- und Faserforschung Denkendorf, erklärt Dir, wie aus harten Strohhalmen weiche Fasern werden.
Mehr InformationenZu Stroh in der Bioökonomie

Reisstroh als Rohstoffquelle nutzen
Bislang werden Ernteabfälle meist verbrannt und setzen CO2 und Feinstaub frei. Geeignete Bioraffinerien könnten das ändern.
Isolierverpackung
Stroh stellt eine nachhaltige Alternative zu den handelsüblichen Isolierverpackungen aus Styropor dar und ermöglicht es somit, den Verpackungsmüll deutlich zu reduzieren.
Mikrobielles Öl als Palmölersatz
Auf der Basis von Maisstroh wollen Forschende mithilfe des Brandpilzes Ustilago maydis ein Öl kreieren, das künftig Palmöl ersetzen kann.
Preiswertes Bioethanol aus Reststoffen
Forschende der TU München haben mit finnischen Kollegen ein Verfahren entwickelt, um aus Stroh oder Holzresten sowie Ökostrom nachhaltige Kraftstoffe zu produzieren.
Stroh zu Milchsäure
Das Kölner Unternehmen wird durch das Bundeswirtschaftsministerium bei der industriellen Umsetzung seiner innovativen Fermentationstechnologie zur Herstellung von L-Milchsäure unterstützt.
2.4 Biobasierte Stoffe/Materialien (Labor) Banane und Lauch
Lauch und Banane
Ihre biologische Abbaubarkeit macht sie zu einer nachhaltigen Alternative zu synthetischen Fasern, wobei der Ressourceneinsatz für Anbau, Aufzucht und Weiterverarbeitung im Detail zu berücksichtigen ist.
Die Produktion von Baumwollfasern geht beispielweise meist mit einem hohen Einsatz von Wasser, Pestiziden und Insektiziden einher. Die Verarbeitung von Flachsfasern zu Leinengewebe erfordert viel Energie für das Spinnen, Weben und Färben.
Stammen natürliche Fasern von Pflanzen, die nicht nur für diesen einen Zweck angebaut werden, verringert sich der Ressourcenfußabdruck. Die innovative Nutzung solcher Nebenprodukte oder Reststoffe ist weltweit Gegenstand von Forschungsarbeiten.
Die Pflanzen-Protagonisten dieses Kapitels sind Lauch und Banane.
Lauch und Banane
Mehrere Modefirmen nutzen den Stoff bereits und fertigen daraus widerstandsfähige Arbeitshosen, Taschen oder Rucksäcke.
Lauch und Banane
Auf Laufbändern wird der Lauch im Ganzen gewaschen, anschließend zurechtgeschnitten und von verwelkten, ungenießbaren Blättern befreit. Im Regelfall werden die gereinigten Reststoffe nun automatisch gesammelt und einer Kompostanlage zugeführt.
Entfällt der letzte Schritt, liegt ein natürliches Ausgangsprodukt vor, das sich wegen seiner hohen Faserdichte besonders gut für textile Einsätze eignet.
Weitere Vorzüge bieten die Pflanzensäfte des Lauchs, die nach kurzem Aufkochen und Zerfasern des Materials selbst einen biologischen Klebstoff bilden. Dieser ist stark genug, um die zerkleinerten Fasern in Form zu halten, auf synthetische Bindemittel kann verzichtet werden.
Lauch und Banane
Die Untersuchung des Materials führte Maximilian auf theoretischer, vor allem aber auf praktischer Basis aus.
Dabei entschied er sich aus folgenden Gründen für die Herstellung einer Sandale: Schuhe bestehen in den meisten Fällen aus vernähten und vernieteten Materialien, die ein Recycling der Einzelkomponenten meist unmöglich machen. Durch den Abrieb der Sohlen gelangt Mikroplastik in Ökosysteme und bei Lederschuhen kommen meist noch umweltschädigende Gerbverfahren hinzu.
All diese Nachteile bleiben bei biobasierten Schuhen aus. Sie kann man am Ende ihrer Nutzung in der Biotonne entsorgen und so in einen bestehenden Rohstoffkreislauf einfügen.
Und so wird die Lauch-Sandale hergestellt ...
Lauch und Banane
Um die Herstellung zu skalieren, ist eine Integration in bestehende Industriestrukturen notwendig.
1. Die Lauchreste werden mit Wasser unter Rühren aufgekocht, zerkleinert und zu einer homogenen Pulpe vermengt.
2. Das Wasser wird abgelassen, die Pflanzenreste abgeschöpft.
Lauch und Banane
4. Es folgt ein Trockenvorgang im Backofen.
5. Nach Abkühlen wird das Lauchobjekt vorsichtig aus der Form entfernt.
6. Um die Schuhe vor Feuchtigkeit und Schmutz zu schützen, trägt man eine Schicht aus tierischem oder pflanzlichem Fett auf.
Lauch und BananeT-Shirt aus Holz
Zum Beispiel Holz, wie Du in diesem Video aus unserem bioökonomie.de-YouTube-Kanal sehen kannst.
Mehr InformationenZu biologischen Fasern in der Bioökonomie

Autotüren öffnen mit Biotech-Seidefasern
Türgriffschlaufen aus Biotech-Spinnenseide-Fasern von AMSilk werden künftig zum Interieur eines visionären E-Autos von Mercedes-Benz gehören.
Beschichte Flachsfasern für neue Bioverbundwerkstoffe
Ein spezielles Verfahren macht Naturfasern hitzebeständiger und ermöglicht so die Verwendung in technischen Thermoplasten.
Innovationspreis für Carbonfasern aus Holz
Ein von Forschenden der Zuse-Gemeinschaft entwickeltes Verfahren zur Herstellung von Hightech-Fasern aus Laubholz ist mit einem Innovationspreis ausgezeichnet worden.
Weizenstroh in Textilfasern verwandeln
Hamburger Forschende wollen neue Rohstoffquellen zur Gewinnung von Cellulosefasern für die Textilindustrie erschließen und nehmen dafür Stroh ins Visier.
Neuer Faserverbundwerkstoff aus Biopolymeren
Ein Forschungsverbund hat eine nachhaltige Alternative entwickelt, um Organosheets herzustellen.
2.5 Fasern aus Fermentation
Fasern aus Fermentation
Bestimmte Arten all dieser Gruppen von Mikroorganismen spielen für die Bioökonomie eine große Rolle. Sie können biologische Stoffe ab- und aufbauen, dadurch Kreisläufe schließen und ganz neue Produkte mit besonderen Eigenschaften hervorbringen. Diesen Vorgang nennt man auch Fermentation.
Hier erfährst Du mehr darüber!
Fasern aus FermentationWas ist ein Bioreaktor?
Mehr InformationenZu Mikroorganismen und Fermentation

Algen als grüne Wasserstoff-Produzenten
Ein deutsch-japanisches Forschungsteam will Algen dazu befähigen, grünen
Wasserstoff ohne Photosynthese auch nachts zu produzieren.
Von Kimchi, Käse und Aromen: Fermentation im Trend
Bei der zweiten Ausgabe von Bioökonomie im Gespräch im Rahmen der Ausstellung NaturFutur standen nützliche Mikroben im Mittelpunkt – als vielseitige Helfer in der Küche und als industrielle Produzenten von Lebensmitteln und Chemikalien.
Mikrobielle Zellfabriken
Dieses Dossier rückt die winzigen Leistungsträger der industriellen Biotechnologie ins Rampenlicht. Für die Kurzporträts bedeutender Bakterien, Hefen und Schimmelpilze hat bioökonomie.de zahlreiche Fachleute als Steckbriefpaten gewonnen.
GEA eröffnet Pilotanlage für alternative Protein-Produktion
Mit einem Technologiezentrum für Pilotprozesse zur Produktion alternativer Proteine will der Anlagenbauer GEA Lebensmittel-Innovationen vorantreiben.
Mikroalgen-Zucht im Bioreaktor überzeugt
Die Kultivierung von Mikroalgen zur Produktion von Omega-3-Fettsäuren in Photobioreaktoren ist gegenüber der Fischzucht in Aquakultur umweltfreundlicher, wie eine Studie zeigt.
Pelz aus Stammzellen
Die Nachfrage nach Pelz führt oft zur Ausbeutung von Wildtieren und zum Verlust von Lebensräumen, was die Artenvielfalt beeinträchtigt. Zuchttiere in Pelzfarmen leiden häufig unter Stress und zeigen Verhaltensstörungen.
Über allem steht die Frage, ob Tiere generell für ein nicht essenzielles menschliches Bedürfnis aufgezogen und getötet werden sollten.
Hinzu kommen ökologische Nachteile: Die Aufzucht der Tiere ist ressourcenintensiv und beim Gerben des Pelzleders kommen meist schädliche Substanzen zum Einsatz, die Mensch und Umwelt schaden können. Der Betrieb von Pelzfarmen geht mit einem hohen Energieeinsatz einher und aufgrund von schlechten Haltungsbedingungen kommt es in diesen Betrieben relativ häufig zu Krankheitsausbrüchen.
Beim Pelz-Haargummi der Wissenschaftlerin überwiegen jedoch die Vorteile. Wie kann das sein?
Pelz aus Stammzellen
Dabei zeigt er auf, dass von den innovativen Biotechnologieverfahren nicht nur der Lebensmittelsektor, sondern auch die Textil- und Bekleidungsindustrie profitieren kann.
Mehr InformationenZu Stammzellen in der Bioökonomie

Pluripotente Stammzellen vom Schwein
Ein internationales Forscherteam hat eine besondere Variante pluripotenter Stammzellen von Schweinen gewonnen. Sie bergen Potenzial für die Landwirtschaft und die Medizin.
Stammzellen bilden Holz und Bast
Heidelberger Forscher fanden heraus, dass die wirtschaftlich wichtige Holzbildung von Stammzellen gesteuert wird, die abwechselnd Holz und Bast produzieren.
Forschung für nachhaltige In-vitro-Produktion
Ein neues Forschungsnetzwerk unter Leitung des Forschungsinstituts für Nutztierbiologie will die Herstellung von zellbasiertem Fleisch von Antibiotika und fötalem Kälberserum unabhängig machen.
Sauerstoffarme Stammzellnische
Pflanzenstammzellen in der obersten Wachstumsspitze der Sprossachse benötigen eine Umgebung mit niedriger Sauerstoffkonzentration, wie Forscher aus Aachen und Heidelberg berichten.
Algen-Gelee lässt Stammzellen gedeihen
Aus zwei Algenarten von der chilenischen Küste gewinnen Fraunhofer-Forscher einen vielversprechenden Nährboden für die Vermehrung pluripotenter Stammzellen.
3.1 Färben mit Pflanzenresten
Farben aus Resten
Traditionell nutzt man Pflanzen und ihre Bestandteile (Blätter, Wurzeln etc.) außerdem schon seit vielen Jahrhunderten als natürliche Färbemittel.
Immer mehr Unternehmen, die auf Nachhaltigkeit setzen, machen sich dieses traditionelle Verfahren zunutze und entwickeln daraus ein Geschäftsmodell: Sie produzieren biologische Pigmente und verkaufen sie an Färbereien.
Mit Avocado-Schalen und -Kernen erzeugen die Hersteller beispielweise einen zarten Rosa- oder Pfirsichton, während Walnussschalen dunkle Brauntöne liefern können. Kurkuma, Spinat, Rote Beete und viele andere Pflanzen bieten ebenfalls eine Palette von Farben, die von Gelb über Grün bis hin zu Rottönen reichen.
Mehr InformationenZu pflanzlichen Reststoffen in der Bioökonomie

Möbel aus Gärresten bauen
Pflanzliche Gärreste aus der Biogasanlage haben Forschende vom Deutschen Institut für Textil- und Faserforschung Denkendorf mit Industriepartnern zu einem Verbundwerkstoff verarbeitet und daraus ein Möbelstück hergestellt.
Milchalternative
Die Nachfrage nach pflanzlichen Milchalternativen ist in den vergangenen Jahren deutlich angestiegen. Von 2018 bis 2020 verdoppelte sich der Absatz in Deutschland. Seitdem hat die Entwicklung noch einmal Fahrt aufgenommen.
Versandtaschen aus neuem Biokunststoff
Fraunhofer-Forschende haben die Palette nachhaltiger Biokunststoffe um einem neuen Typ von Polybutylensuccinat (PBS) erweitert und daraus ein erstes Produkt hergestellt.
Dämmen mit Pilzmycel und Pflanzenresten
Pilz- und pflanzenbasierte Rohstoffe könnten Polyesterschäume und Verbundstoffe auf Mineralbasis ersetzen.
Biobasierte Schaumstoffe aus Agrarresten
Im EU-Projekt BIOMAT arbeiten Forschende aus acht EU-Staaten, darunter Deutschland, an nachhaltigen Schaum- und Verbundwerkstoffen, die zu mehr als der Hälfte aus nachwachsenden Rohstoffen bestehen.
3.2 Färbemittel & Füllmaterialien (Gewächshaus) schwarze Algen
Färben mit Algen
Das Färben mit Algen ist im Allgemeinen umweltfreundlicher als herkömmliche chemische Färbemethoden.
Es beginnt damit, dass Algen kultiviert und geerntet werden. Anschließend muss man die Farbstoffe aus ihnen extrahieren. Diese Extrakte können dann auf verschiedene Materialien wie Stoffe, Garne oder Fasern aufgetragen werden. In der Regel ist auch noch eine Behandlung nötig, um die Farbe dauerhaft zu fixieren.
Färben mit Algen
Jörg Ullmann, Diplom-Biologe und Geschäftsführer der Algenfarm Klötze GmbH, gibt in diesem kurzen Video einen kleinen Einblick in den professionellen Anbau seiner Mikroalgen.
In transparenten Röhrensystemen bekommen die Algen ausreichend Licht und werden über ein Pumpsystem mit Sauerstoff und Nährstoffen versorgt.
Färben mit Algen
Ein großer Vorteil gegenüber Pflanzen ist, dass Algen keine Erde zum Wachsen brauchen. Deshalb kann man sie auch in Wüsten, auf Dächern oder auf alten Industriegeländen anbauen. So nehmen sie keinen wertvollen Boden in Anspruch, der auch für die Lebensmittelproduktion genutzt werden könnte. Ein Anbau von Makroalgen im Meer kann diesem einen Überschuss an Nährstoffen entziehen und so die Artenvielfalt schützen.
Zusätzlich ist Algenzucht, besonders in geschlossenen Systemen, sehr wassereffizient. Die Nährstoffe, welche die Algen für ihr Wachstum brauchen, werden im besten Fall aus Abwässern zurückgewonnen. So können nachhaltige Kreislaufsysteme entstehen.
Mehr InformationenZu Algen in der Bioökonomie

Algen als grüne Wasserstoff-Produzenten
Ein deutsch-japanisches Forschungsteam will Algen dazu befähigen, grünen
Wasserstoff ohne Photosynthese auch nachts zu produzieren.
LaborAlgen
Mit Algen kann man Energie erzeugen, Schaumstoff herstellen und Kosmetik
anreichern. Für welche Zwecke René Inckemann Algen einsetzt, erfährst du in diesem Video.
Algenanbau im Meer
Die Ostsee künftig als Ackerfläche nutzen – an dieser Vision arbeiten Forschende der Universität Rostock und nehmen dafür Algen ins Visier.
Algen-Tampon
Herkömmliche Einwegtampons bestehen bis zu 90% aus Kunststoff – sie sind damit nicht nur schädlich für die Umwelt, sondern auch für die Gesundheit der Tragenden. Ein neuer Tampon bietet eine nachhaltige Alternative.
Chemie-Rohstoffe aus der Algenfarm
Das Start-up MacroCarbon will auf Gran Canaria die Makroalge Sargassum in Algenfarmen züchten und Grundstoffe für die chemische Industrie liefern. Die Agentur für Sprunginnovationen SPRIND unterstützt das Projekt.
3.3 Kolorieren mit Kräutern
Kolorieren mit Kräutern
In der Textilwirtschaft spielen Kräuter bisher eine untergeordnete Rolle. Ihr Potenzial für umweltfreundliche Färbeprozesse wird jedoch von immer mehr (kleinen) Unternehmen erkannt und erforscht.
Während bei den meisten das Potenzial der Kräuter als biobasierte Mittel zum Kolorieren im Vordergrund steht, gehen andere noch einen Schritt weiter.
Ihr Ziel ist es, die Vorzüge aus beiden Einsatzgebieten zu kombinieren: Farbpigmente ohne Toxine herstellen, die ihre gesundheitsfördernden Eigenschaften beim Tragen der kolorierten Kleidungsstücke über die Haut an die Person abgeben.
Mehr InformationenZu (Un-)Kräutern in der Bioökonomie

Pflanzenvielfalt hält Unkräuter im Zaum
Der Anbau verschiedener Kulturpflanzen auf dem Acker kann verhindern, dass unliebsame Unkräuter überhandnehmen und Erträge schmälern.
Kräuteranbau im Supermarkt
Das hydroponische System des Berliner Start-ups Infarm bringt die Landwirtschaft in die Stadt. Das spart Rohstoffe und vermeidet Emissionen.
Zuckerrüben von Unkräutern befreien
Ein Feldroboter, der beim Zuckerrübenanbau selbstständig Unkräuter erkennt und entfernt, hat in der Uckermark einen ersten Testlauf erfolgreich bestanden.
Gesunde Wurst dank Kräuter-Mix
Lebensmitteltechnologen der Hochschule Anhalt haben gesunde Wurstsorten entwickelt: Gewürze wurden durch Heilkräuter ersetzt, die Magen-Darm-Erkrankungen nachweislich vorbeugen können.
Neue Fusion im Green-Farming-Bereich
Das US-Unternehmen Kalera erwirbt Aktienanteile in Millionenhöhe am Münchner Indoor-Farming-Spezialisten &ever und will damit seine globale Marktposition im Bereich vertikale Landwirtschaft weiter ausbauen.
3. Färbemittel & Füllmaterialien (Gewächshaus)
Farben aus Resten
Färben mit Algen
Kolorieren mit Kräutern
Mit Bakterien tönen
Kapok-Daunen
Hundewolle
Zurück zur Übersicht
3.4 Mit Bakterien tönen
Mit Bakterien tönen
Weniger bekannt ist ihr potenzieller Nutzen für die Textilindustrie. Einige Bakterien sind in der Lage, Farben zu produzieren – als Schutzfunktion vor äußerem Stress oder in Zusammenhang mit Fortpflanzungsstrategien. Die Funktionen variieren zwischen den Bakterien ebenso stark, wie die Farbtöne, die sie herstellen können.
Die bakterielle Färbung eint, dass sie sehr umweltfreundlich und ressourcenschonend ist. Geeignete Bakterien finden sich beispielsweise in der Luft, im Boden oder in Gewässern. Es wird kein Ackerland benötigt, die Bakterien können in Laboren lagern und jederzeit vermehrt werden.
Biodesignerin Julia Moser zählt zu jenen, die sie vermehren ...
Mit Bakterien tönenZur Forschung mit Pigmentbakterien: vier kurze Videos
Mehr InformationenZu Bakterien in der Bioökonomie

Mikrobielle Zellfabriken
Dieses Dossier rückt die winzigen Leistungsträger der industriellen Biotechnologie ins Rampenlicht. Für die Kurzporträts bedeutender Bakterien, Hefen und Schimmelpilze hat bioökonomie.de zahlreiche Fachleute als Steckbriefpaten gewonnen.
Bakterien nutzen Wasserstoff für Biosynthese
Jenaer Leibniz-Forschende haben nachgewiesen, dass Bakterien Wasserstoff für mikrobielle Elektrosynthesen nutzen.
Bioabbaubares Mikroplastik reichert Bodenbakterien an
Je kleiner und zahlreicher die Partikel sind, desto mehr Mikroorganismen ernähren sich davon – und setzen CO2 frei.
Die guten Mitbewohner
Bakterien, die in und auf Pflanzen siedeln und schädliche Organismen wie pflanzenpathogene Pilze und Fadenwürmer fernhalten, sollen chemische Pestizide ersetzen.
Neues Antibiotikum gegen Pflanzenkrankheiten
Ein neuer Wirkstoff aus Bakterien könnte im Pflanzenschutz helfen, hat aber auch Potenzial für die Humanmedizin.
Mit Bakterien tönenEinleitung
Mit Bakterien tönenDie Entdeckung der Pigmentbakterien
Mit Bakterien tönenWarum ist Bakterienfärbung nachhaltig?
Mit Bakterien tönenDie Forschung mit Pigmentbakterien
Kommen bakterielle Färbemittel bei Textilunternehmen bereits zum Einsatz?
Mehr dazu in dieser Videosequenz.
3.5 Kapok-Daunen
Kapok-Daunen
Mit seinen hohlen Stämmen bietet er nicht nur zahlreichen Tierarten wie Vögeln, Fledermäusen und Insekten Lebensraum, sondern er lockt mit seinen auffälligen Blüten auch eine Vielzahl von Bestäubern an.
Die Kapselfrüchte des Baums tragen zur Verbreitung von Samen bei, indem sie diese über Wind oder Tiere in neue Gebiete transportieren. Dadurch wird die genetische Vielfalt gefördert und das Wachstum anderer Pflanzen unterstützt.
Darüber hinaus spielen die abfallenden Blätter und Früchte eine entscheidende Rolle bei der Anreicherung des Bodens mit Nährstoffen und sie tragen zur Verhinderung Erosion bei.
Im Inneren der Früchte verbirgt sich ein natürlicher Rohstoff, der in der Modeindustrie an Bedeutung gewinnt ...
Kapok-Daunen
Diese Eigenschaften machen die Fasern zu einem geeigneten tierfreien Daunenersatz, der in manchen Ländern schon seit vielen Jahrzehnten genutzt wird.
Eine niederländische Firma hat diese Tradition zu einem nachhaltigen Geschäftsmodell weiterentwickelt und bietet das biobasierte Material für unterschiedliche Anwendungen an – vom Füllstoff für Daunenschals bis zum Bestandteil von Verbandsmaterialien.
Um die Fasern zu gewinnen, wird der Baum nicht beschädigt. Es werden nur die Früchte geerntet. Die weltweite Nachfrage nach Daunen kann auf diese Weise nicht gestillt werden. Gemeinsam mit anderen biologischen Alternativen – wie etwa Rohrkolben – stellt der Kapokbaum jedoch eine umweltfreundliche Ergänzung dar.
Mehr InformationenZu biobasierten Füllstoffen

Spargelschalen für Biokunststoffe nutzen
Mit Blick auf eine kreislauffähige Bioökonomie untersuchen Forschende am IfBB, ob Spargelschalen als Füllstoffe für Bioverbundwerkstoffe geeignet sind.
Ziegeldämmstoff aus Buchenholzfasern
Bis 2025 soll im mecklenburgischen Teterow eine Pilotanlage zur Nutzung von Buchenholzfasern als Ziegeldämmstoff entstehen.
Bio-Verbundstoff aus Flachs und Chitosan
Forschende haben einen neuen Bio-Verbundwerkstoff entwickelt, der aus CO2-neutralen Rohstoffen besteht und biologisch abbaubar ist.
Nachhaltige Rohstoffe für Elastomere
Vom Basismonomer bis zum Additiv soll die wichtige Kunststoffgruppe bio- oder reststoffbasierter werden.
Vielseitige Verbundwerkstoffe aus Kaffeesatz
Kaffeesatz ist mehr als nur Abfall, nämlich ein kostbarer Rohstoff, der zu neuen biobasierten Verbundwerkstoffen verarbeitet werden kann. In dem Ideenwettbewerb-Projekt BioKaVe wurde dafür ein Aufbereitungsverfahren entwickelt.
3.6 Nutzung von Hundehaaren
HundewolleTiere als Wollelieferanten
Schafswolle bietet zahlreiche Vorteile als biobasiertes und vielseitiges Material. Sie isoliert effektiv gegen Kälte und Hitze, reguliert Feuchtigkeit, ist geruchsneutralisierend und hypoallergen. Zudem ist sie besonders robust und natürlich biologisch abbaubar.
Vorzüge, die sich Schafswolle komplett oder teilweise mit der Wolle von Kaschmir- und Angoraziegen sowie Kamelen und Lamas teilt.
Darüber hinaus eignet sich jedoch auch das Unterfell eines beliebten Haustieres für die Herstellung eines besonders weichen Garns ...
Hundewolle
Ein geringfügiger Teil dieses Aufkommens wird von Kleinunternehmen für die Herstellung von Garn genutzt. Besonders ergiebig und geeignet ist das Unterfell von langhaarigen, voluminösen Rassen wie beispielsweise Collies, Neufundländer und Spitze.
Die Verarbeitung der Hundehaare, die häufig von Privatpersonen oder Hundesalons stammen, beginnt mit einem gründlichen Wasch- und Trockenvorgang.
Eine sogenannte Kardiermaschine richtet die Haare einheitlich in eine Richtung aus, bevor das Spinnen zu Garn erfolgt.
Die Wolle ist nun bereit, mit Naturfarben koloriert und zum Beispiel zu Folgendem weiterverarbeitet zu werden...
Hundewolle
Andere Unternehmen fertigen daraus zum Schals und Mützen oder mischen es Unterhemden bei.
Hundewolle spielt auf dem globalen Modemarkt im Grunde keine Rolle und führt bisher nur ein Nischendasein. Das zunehmende Interesse vieler Kunden nach mehr Regionalität und natürlichen Materialien könnte daran langfristig etwas ändern.
Mehr InformationZu ressourcenschonendem Tierfutter

Lupinen als Tierfutterersatz
Der Anbau von Lupinen könnte die Landwirtschaft unabhängiger von Eiweißfutterimporten machen. Dafür werden aber neue Züchtungen benötigt, wie eine Umfrage der ZALF ergab.
Proteinfutter aus der On-Farm-Bioraffinerie
Forschende der Universität Hohenheim wollen Proteine aus Pflanzen von Wiesen und Weiden für die Bioökonomie nutzbar machen. Ein Proteinextrakt für Futtermittel konnte daraus bereits gewonnen werden.
Mikroben-Proteine als Tierfutter
Von Mikroorganismen hergestellte Proteine könnten künftig als umweltschonender Ersatz für Kraftfutter im Tiertrog dienen. Das haben Potsdamer Klimaforscher in einer Studie untersucht.
Getoastete Futtererbsen als Sojaersatz
Tierfutter muss proteinreich sein, weshalb Soja sehr gut dafür geeignet ist. Aus ökologischen Gründen suchen Forscher nach heimischen Alternativen.
Insekten als Rohstoff und Futterquelle
Innovative, wettbewerbsfähige Produkte aus Insektenmehl sind Ziel des Projekts „Competitive Insect Products“. Insekten liefern nicht nur proteinreiches Tierfutter. Ihre Fette können auch als Rohstoffe für die Industrie dienen.
4. Schutzfilme (Werkstatt)
Schutz mit Chitosan
Pfefferminz-Frische
Biobasiert imprägnieren
Recycling mit Enzymen
Schutz mit Lignin
Biotech-Nagellack
Zurück zur Übersicht
4.2 Chitosan Schutz
Schutz mit Chitosan
Von Natur aus verfügen diese Polymere unter anderem über diese Merkmale:
Ihre antimikrobielle Wirkung hemmt die Bildung von Mikroorganismen wie Bakterien, Viren und Pilzen. Mit Blick auf den Bekleidungsbereich kann auf diese Weise zum Beispiel Schweißgeruch, im Pflegesektor die Verbreitung von Krankheitserregern gemindert werden.
Auf Oberflächen aufgetragen, unterstützen sie die Absorption schädlicher UV-Strahlung und sie wehren allergene Organismen, wie Hausstaubmilben ab. Im Gegensatz zu erdölbasierten Polymeren sind Chitosan und Chitin außerdem biologisch abbaubar und hinterlassen somit keine Rückstände in der Natur.
In der Wissenschaft nehmen die beiden natürlichen Polymere inzwischen einen prominenten Platz ein, etwa im Rahmen des Forschungsprojekts ExpandChi.
Schutz mit ChitosanDas Projekt ExpandChi
Ihre Forschung dazu ist Bestandteil des Projekts ExpandChi, welches vom Bundesministerium für Bildung (BMBF) gefördert wird.
Mehr InformationenZu Chitin und Chitosan in der Bioökonomie

Bio-Verbundstoff aus Flachs und Chitosan
Forschende haben einen neuen Bio-Verbundwerkstoff entwickelt, der aus CO2-neutralen Rohstoffen besteht und biologisch abbaubar ist.
Biobasierte Verpackungsfolien für Lebensmittel
Partner aus Forschung und Wirtschaft wollen mehrlagige Verpackungsmaterialien auf Basis von Chitosan entwickeln und zugleich eine entsprechende Methode zur Qualitätskontrolle erarbeiten.
Den Chitin-Code knacken
Wie wird Chitin von der Natur erzeugt? Diese Fragen wollen Forschende beantworten, um das Biopolymer für die Medizin nutzbar zu machen.
Mit Chitosan Gewässer reinigen
Dresdner Leibniz-Forschern ist es erstmals gelungen, verockerte Gewässer wieder aufklaren zu lassen: Sie nutzten dazu das Biopolymer Chitosan als Flockungsmittel.
Eine Batterie aus nachwachsenden Rohstoffen
Forscher des Max-Planck-Instituts für Kolloid- und Grenzflächenforschung arbeiten daran, für jede Komponente der ökologisch problematischen Stromspeicher nachhaltige Alternativen zu entwickeln.
4.3 Schutzfilme (Werkstatt) Pfefferminzöl
Pfefferminz-Frische
In diesen und in den Stängeln befindet sich das ätherische Öl, welches für zahlreiche Anwendungen eingesetzt werden kann. Wegen seiner antibakteriellen Eigenschaften nutzt man es vor allem im Gesundheitsbereich, etwa bei Atemwegsinfektionen oder Magen-Darm-Beschwerden.
In der Textilindustrie kommt Pfefferminze ebenfalls zur Anwendung – wenn auch noch in kleinem Maßstab. Von Interesse sind dabei nur am Rande ihre Fasern, die für die Herstellung biobasierten Garns genutzt werden können. Auch hier steht vor allem das ätherische Öl im Fokus …
Pfefferminz-Frische
An dieser Stelle kommt Pfefferminzöl ins Spiel. Dieses wird zuerst in einem schonenden Dampfverfahren ohne den Einsatz von Lösungsmitteln oder anderen Chemikalien aus den Pflanzenbestandteilen extrahiert.
Auf natürliche Textilfasern aufgetragen, neutralisiert und verhindert es das Wachstum von geruchsverursachenden Bakterien. Die Stoffe bleiben länger frisch und sie müssen seltener gewaschen werden.
Die biologische Beschichtung hält 50 Waschgänge und kommt bereits bei einigen Bekleidungsfirmen zur Anwendung.
Mehr InformationenZu ätherischen Ölen in der Bioökonomie

Lavendel als Rohstoff für die Bioökonomie
In der Schwäbischen Alb wollen Forschende Lavendel anbauen, um aus der Pflanze ätherische Öle und Textilfasern zu gewinnen.
Pflanzliche Wirkstoffe veredeln
Wirkstoffe aus Arzneipflanzen wie Thymian und Kamille können dank eines neuen Verfahrens nun noch effektiver genutzt werden.
Ätherische Öle als Viren-und Insektenschutz
Antimikrobielle Textilien, die Insekten oder Viren fernhalten können - diese Idee verfolgen Fraunhofer-Forscher aus Potsdam.
Duftpads für den Biomülleimer
Unangenehme Gerüche und Schimmel schrecken oft vom Sammeln von Biomüll ab. Die WastePads der TerFirmo GbR sollen das ändern: Die saugstarken Einlagen bekämpfen Bakterien mit Teearomen.
Eine flexible Biofabrik zur Terpenherstellung
Forschende haben eine Methode entwickelt, um verschiedene Terpene auf Basis unterschiedlicher Kohlenstoffquellen mithilfe des vielseitigen Mikroorganismus Cupriavidus necator herzustellen.
4.4. Schutzfilme (Werkstatt) Bioschutzfilm ohne PFC
Biobasiert imprägnieren
Meist werden hierfür Chemikalien eingesetzt, die für Tiere und Menschen gesundheitsgefährdend sind und die beim Waschen oder während der Entsorgung teilweise ins Wasser und in die Umwelt gelangen. Dort bleiben sie über lange Zeit stabil und werden unter anderem durch Fische aufgenommen, wodurch die Chemikalien am Ende auch wieder bei uns auf dem Teller landen.
Gibt es hierfür nicht auch biobasierte Alternativen?
Biobasiert imprägnieren
Biobasiert imprägnierenBioSchutz
Dass Imprägnieren auch nachhaltig geht, beweist Dr. Felix Jakob vom DWI – Leibniz-Institut für Interaktive Materialien. In diesem Video stellt er die Forschung des Projektes "BioCoat" vor.
Mehr InformationenZu biologischen Schutzfilmen in der Bioökonomie

Schutzmaske aus bakterieller Cellulose
Zwei Designerinnen aus den USA haben mithilfe von Bakterien einen Mund-Nase-Schutz hergestellt, der Luftpartikel filtert und zugleich biologisch abbaubar ist.
So funktioniert der pflanzliche Sonnenschutz
Auch Pflanzen schützen ihre Zellen durch Farbpigmente vor zu viel Sonne. Das Signal dazu geben Zucker aus der Photosynthese.
Biobasierte Verpackungsfolien für Lebensmittel
Partner aus Forschung und Wirtschaft wollen mehrlagige Verpackungsmaterialien auf Basis von Chitosan entwickeln und zugleich eine entsprechende Methode zur Qualitätskontrolle erarbeiten.
Auf dem Weg zur neuen Biotechnologie?
Forschende wollen die Substrate Zucker und Alkohol durch den günstigeren und nachhaltigen Wasserstoff ersetzen.
Schutzfilm für Biokatalysatoren
Forscher der Universität Bochum haben einen dünnen Schutzfilm für Hydrogenasen entwickelt, der diese sicher vor Sauerstoff schützt. So können die Enzyme in Biobrennstoffzellen überdauern.
4.5 Biobasierte Stoffe/Materialien (Labor) Textil-Recycling
Recycling mit Enzymen
Enzyme sind wichtige Werkzeuge für eine nachhaltige Bioökonomie. Es sind spezialisierte Proteine, die in allen Lebewesen vorkommen und dort ganz unterschiedliche, wichtige Funktionen übernehmen.
Besonders in Mikroorganismen findet man Enzyme, die für ein Recycling von Materialien interessant sind. Manche können zum Beispiel große, stabile Moleküle zerlegen und so die Fasern von Textilien abbauen.
Recycling mit EnzymenProjekt EnzyDegTex
Recycling mit EnzymenKreislaufwirtschaft
In einer Kreislaufwirtschaft hingegen können Ressourcen effektiver genutzt werden. Hier entstehen Stoffkreisläufe, die Rohstoffe schonen und gleichzeitig Abfall und Emissionen vermeiden. Weil sich biologische Rohstoffe hierfür besonders eignen, spielt die Kreislaufwirtschaft in der Bioökonomie eine wichtige Rolle.
Was eine Kreislaufwirtschaft ganz genau ist, erklären wir in unserem Video.
Mehr InformationenZu Enzymen und Kreislaufwirtschaft

Enzyme – die Supertalente der Bioindustrie
Enzyme sind die unsichtbaren Stars der Bioökonomie. Sie sind wichtige Helfer in der Lebensmittelherstellung, aber auch in der Konsumgüterindustrie sind ihre außergewöhnlichen Fähigkeiten gefragt.
Rohstoff-Recycling aus Teppichresten
Mithilfe eines neuartigen Lösungsmittels konnte erstmals aus Teppichabfällen der erdölbasierte Rohstoff Polypropylen zurückzugewonnen werden – und das in höchster Qualität.
Impulse für eine nachhaltige Kreislaufwirtschaft
Die Transformation zu einer Kreislaufwirtschaft in Deutschland hätte positive Auswirkungen auf Klima, Ressourcen und Biodiversität. Das zeigt eine neue Studie, die gleichzeitig Maßnahmen zur Umsetzung benennt.
Entdeckungstour durch eine Bioraffinerie
Auch in Bioraffinerien kommen Enzyme zum Einsatz. In diesen Fabriken der Bioökonomie verarbeiten Mikroorganismen oder zellfreie Systeme biologische Stoffe zu biobasierten Produkten. In einer unserer vorherigen, interaktiven Multimedia-Storys erfährst du mehr darüber.
Textilrecycling mit PET-abbauenden Enzymen
Die französische Carbios schließt sich mit PUMA und weiteren Sportartikel- und Bekleidungsunternehmen zusammen, um eine biotechnologische Kreislaufwirtschaft in der Textilindustrie zu etablieren.
4.6 Biotech-Nagellack
Biotech-Nagellack
Aus der Natur kann man dieses außergewöhnliche biobasierte Material nicht in größeren Mengen gewinnen. Doch Forschenden ist es gelungen, es auf biotechnologischem Wege zu produzieren.
Mikroorganismen wurden so umprogrammiert, dass sie Spinnenseidenprotein herstellen. Inzwischen gibt es zahlreiche Anwendungen dafür. Auch im Nagellack der Forscherin in unserer Illustration befindet sich Spinnenseidenprotein.
Biotech-NagellackFasern aus Spinnenseidenprotein
(Bildquelle: AMSilk)
Multitalent Spinnenseide
Auch für die Herstellung von gut verträglichen Implantaten wird das innovative Material bereits eingesetzt.
(Bildquelle: AMSilk)
Mehr InformationenZu Proteinen in der Bioökonomie

So reguliert das Protein TOR das Wurzelwachstum
Das Signalmolekül TOR erkennt, ob genügend Zucker vorhanden ist, um neue Wurzeln zu entwickeln.
Proteinfutter aus der On-Farm-Bioraffinerie
Forschende der Universität Hohenheim wollen Proteine aus Pflanzen von Wiesen und Weiden für die Bioökonomie nutzbar machen. Ein Proteinextrakt für Futtermittel konnte daraus bereits gewonnen werden.
Das Potenzial der Sonnenblumenproteine
Sonnenblumen bieten für die Agrar- und Lebensmittelproduktion ein enormes Potenzial. Bisher werden sie fast ausschließlich zur Gewinnung von Pflanzenöl angebaut.
Alternative Proteine für glutenfreie Backwaren
Mit Proteinen aus Erbse, Raps, Quinoa und Gänseblümchen wollen Hohenheimer Forschende in Backwaren das Gluten-Protein ersetzen und damit Teigwaren gleichzeitig locker-luftig und nährstoffreich machen.
Bekömmliches Designer-Protein für Phenylketonurie-Patienten
Mit einem biotechnologisch hergestellten Protein, das frei von einer bestimmten Aminosäure ist, will ein Forscherteam die Ernährungsoptionen von Phenylketonurie-Patienten verbessern.
4.7 Schutzfilme (Werkstatt) Schutz Ligninbasis
Schutz mit Lignin
Für den Rucksack aus der Werkstatt unseres Textilcampus kommt Kraftpapier zum Einsatz. Die Vorteile dieses Werkstoffs liegen vor allem in seiner biologischen Abbaubarkeit und dem ressourcenschonenden Herstellungsverfahren mit relativ niedrigem CO₂-Ausstoß.
Hier erfährst Du mehr über Lignin und seine Anwendungsbereiche.
Schutz mit LigninKraftpapier versiegeln
Standardmäßig verwendet man für solch eine Barriereschicht erdölbasierte, chemische Mittel. Dadurch ist das Produkt nicht mehr biologisch abbaubar und Recyclingvorgänge werden erschwert oder sogar verhindert.
Eine biobasierte Lösung für dieses Problem liegt in einer Kombination bestimmter Enzyme und Lignin. Aufgetragen macht dieses Gemisch das Papier widerstandsfähiger, es reduziert den Materialeinsatz und der Werkstoff kann recycelt bzw. biologisch abgebaut werden.
Was Lignin genau ist, wie und woraus es hergestellt wird, und wo es in der Bioökonomie darüber hinaus seine Vorzüge zur Anwendung bringen kann, erfährst Du auf der nächsten Seite. Das Dossier Lignin – Reststoff mit Potenzial an Position 1 bietet dazu einen kompakten Überblick.
Biobasierte Produkte aus LigninSchutz mit Lignin
Mehr Informationen Zur Nutzung von Lignin in der Bioökonomie

Lignin – Reststoff mit Potenzial
Dieses Dossier gibt einen kompakten Überblick über Forschungs- und Entwicklungsprojekte, die neue Anwendungen für Lignin erschließen.
Biobasierte Aerogele aus Lignin
Ein Osnabrücker Start-up hat erstmals Aerogele aus Pflanzenrohstoffen hergestellt, die in der Industrie auch zum Einsatz kommen können – unter anderem als Dämmmaterial.
Raffinierte Chemie aus Holz
Am Fraunhofer-Zentrum für Chemisch-Biotechnologische Prozesse (CBP) arbeiten Forscher daran, pflanzliche Biomasse als nachhaltige Rohstoffquelle für die chemische Industrie zu erschließen: in einer sogenannten Bioraffinerie.
Vanillin-Produktion aus Holz
Mittels eines neuen Oxidationsmittels konnten Mainzer Chemiker das elektrochemische Verfahren zur Herstellung des Aromastoffes Vanillin aus Lignin noch nachhaltiger gestalten.
Innovationspreis für Carbonfasern aus Holz
Ein von Forschenden der Zuse-Gemeinschaft entwickeltes Verfahren zur Herstellung von Hightech-Fasern aus Laubholz ist mit einem Innovationspreis ausgezeichnet worden.





























































































 Der Textilcampus - Startseite
Der Textilcampus - Startseite
 Leder aus dem Labor
Leder aus dem Labor
 Leder aus dem Labor
Leder aus dem Labor
 Leder aus dem Labor
Leder aus dem Labor
 Fleisch aus Zellkultur
Fleisch aus Zellkultur
 Der Laborfischer
Der Laborfischer
 Mehr Informationen
Mehr Informationen
 Sandalen aus Bakterien
Sandalen aus Bakterien
 Sandalen aus Bakterien
Sandalen aus Bakterien
 Infografik Bakterielle Nanocellulose
Infografik Bakterielle Nanocellulose
 Scoby – eine wirksame Symbiose
Scoby – eine wirksame Symbiose
 Start-up ScobyTec auf der HANNOVER MESSE '23
Start-up ScobyTec auf der HANNOVER MESSE '23
 Mehr Informationen
Mehr Informationen
 Ledrige Algen
Ledrige Algen
 Ledrige Algen
Ledrige Algen
 Küste - Lederalternativen
Küste - Lederalternativen
 Wundergewebe Chitin
Wundergewebe Chitin
 Wundergewebe Chitin
Wundergewebe Chitin
 Wundergewebe Chitin
Wundergewebe Chitin
 Kokos für Taschen
Kokos für Taschen
 Kokos für Taschen
Kokos für Taschen
 Pflanzliche Lederalternativen
Pflanzliche Lederalternativen
 Leder aus Blättern
Leder aus Blättern
 Leder aus Blättern
Leder aus Blättern
 Der Baubotaniker
Der Baubotaniker
 Gedruckte Laborbrillen
Gedruckte Laborbrillen
 3D-Druck in der Bioökonomie
3D-Druck in der Bioökonomie
 Einsatz in der Pflanzenforschung
Einsatz in der Pflanzenforschung
 Pflanzenforschung im Weltraum
Pflanzenforschung im Weltraum
 Tortenkunst aus dem 3D-Drucker
Tortenkunst aus dem 3D-Drucker
 Wurzelkleid
Wurzelkleid
 Wurzelkleid
Wurzelkleid
 Mit Wurzeln kreativ werden
Mit Wurzeln kreativ werden
 Labor
Labor
 Fasern aus Stroh
Fasern aus Stroh
 Fasern aus Stroh
Fasern aus Stroh
 Fasern aus Stroh
Fasern aus Stroh
 Lauch und Banane
Lauch und Banane
 Lauch und Banane
Lauch und Banane
 Lauch und Banane
Lauch und Banane
 Lauch und Banane
Lauch und Banane
 Lauch und Banane
Lauch und Banane
 Lauch und Banane
Lauch und Banane
 T-Shirt aus Holz
T-Shirt aus Holz
 Fasern aus Fermentation
Fasern aus Fermentation
 Was ist ein Bioreaktor?
Was ist ein Bioreaktor?
 Infografik Fermentation
Infografik Fermentation
 CO2 als Rohstoff
CO2 als Rohstoff
 Pelz aus Stammzellen
Pelz aus Stammzellen
 Pelz aus Stammzellen
Pelz aus Stammzellen
 Fleisch aus Zellkultur
Fleisch aus Zellkultur
 Farben aus Resten
Farben aus Resten
 Färben mit Algen
Färben mit Algen
 Infografik Färben mit Algen
Infografik Färben mit Algen
 Färben mit Algen
Färben mit Algen
 Kolorieren mit Kräutern
Kolorieren mit Kräutern
 Kolorieren mit Kräutern
Kolorieren mit Kräutern
 Übersicht (Grafik von Pia)
Übersicht (Grafik von Pia)
 Mit Bakterien tönen
Mit Bakterien tönen
 Mit Bakterien tönen
Mit Bakterien tönen
 Einleitung
Einleitung
Die Entdeckung der Pigmentbakterien
Die Entdeckung der Pigmentbakterien
 Warum ist Bakterienfärbung nachhaltig?
Warum ist Bakterienfärbung nachhaltig?
 Die Forschung mit Pigmentbakterien
Die Forschung mit Pigmentbakterien
 Kapok-Daunen
Kapok-Daunen
 Kapok-Daunen
Kapok-Daunen
 Hundewolle
Hundewolle
 Hundewolle
Hundewolle
 Hundewolle
Hundewolle
 Werkstatt
Werkstatt
 Schutz mit Chitosan
Schutz mit Chitosan
 Das Projekt ExpandChi
Das Projekt ExpandChi
 Pfefferminz-Frische
Pfefferminz-Frische
 Pfefferminz-Frische
Pfefferminz-Frische
 Biobasiert imprägnieren
Biobasiert imprägnieren
 Biobasiert imprägnieren
Biobasiert imprägnieren
 BioSchutz
BioSchutz
 Recycling mit Enzymen
Recycling mit Enzymen
 Projekt EnzyDegTex
Projekt EnzyDegTex
 Kreislaufwirtschaft
Kreislaufwirtschaft
 Biotech-Nagellack
Biotech-Nagellack
 Infografik Spinnenseide
Infografik Spinnenseide
 Fasern aus Spinnenseidenprotein
Fasern aus Spinnenseidenprotein
 Multitalent Spinnenseide
Multitalent Spinnenseide
 Schutz mit Lignin
Schutz mit Lignin
 Schutz mit Lignin
Schutz mit Lignin
 Schutz mit Lignin
Schutz mit Lignin